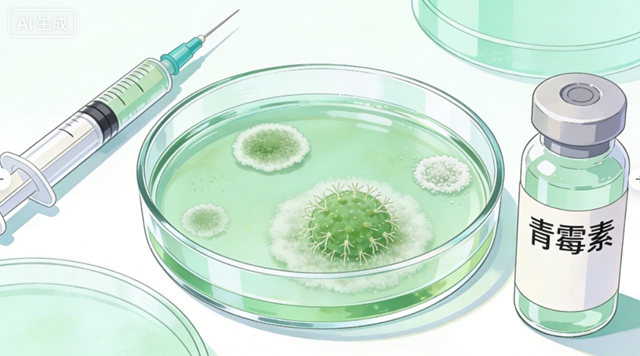
痛5.jpg

川南在线 发布时间:2026-01-30
近日,一则新闻让人揪心——一名4岁女孩确诊“梅毒”,令人震惊的是,传染源竟来自生活中最亲近的人:她的奶奶。

最开始女童家长发现,女孩全身出现不痛不痒的红疹子,当地医院初步诊断为过敏。但用了一段时间抗过敏药物后,症状不仅未缓解,红疹子反而持续增多。转到上级医院检查后,医生发现女孩手心和脚心的红疹子形态特殊,特别像二期梅毒疹。经过相关检查确认,女孩被确诊为后天性梅毒。

经排查,传染源最终锁定女孩奶奶。原来奶奶本身患有梅毒,一直没有进行系统治疗,日常还频繁用嘴给女孩喂饭,导致了梅毒传播。其实,梅毒通过唾液传播的概率极低,可碰巧奶奶牙龈出血,女孩口腔内又有破口,梅毒便通过唾液间接传染。
据西南医科大学附属中医医院皮肤科医生介绍:梅毒是由梅毒螺旋体感染引起的慢性、系统性的性传播疾病。可累及人体多系统多脏器,产生多种多样的临床表现,最终导致组织破坏、功能失常甚至危及生命。
梅毒病程分为一期、二期、三期,早期症状很容易与过敏、皮肤病混淆。其中一期梅毒和二期梅毒具有高度传染性。

一期:感染后约3-4周,会长不痛的溃疡(硬下疳),常出现在生殖器、肛门或口腔等接触部位,附近的淋巴结会肿,一般不痛。
二期:硬下疳出现后的6至12周开始。一期的溃疡(硬下疳)消退后,出现全身症状(低热、乏力、头痛),核心症状是梅毒疹,身上会长红斑、丘疹、水疱等多形性皮疹,可能伴随脱发、黏膜斑,症状反复。
三期:晚期,也是最危险的阶段。如果不及时治疗,随病程进展,会侵犯全身器官,导致皮肤黏膜溃疡性病变、骨骼损伤、心血管疾病、神经系统损伤,严重时危及生命,且治疗难度极大。
梅毒还有哪些传播途径?
1.母婴传播:患有梅毒的孕妇,可能在怀孕或分娩过程中,将梅毒传给胎儿或新生儿。
2.血液传播:输入梅毒感染者的血液、共用被污染的注射器,或使用被污染的医疗器械。
3.间接接触传播:感染者与他人共用餐具、用嘴喂饭、亲吻等,若双方均存在口腔黏膜破损,梅毒可能通过唾液传播。

4.其他情况:人们有时会因接触到梅毒患者的溃疡而受到感染。但梅毒螺旋体不能在人体外长时间存活,因此健康人通常不会因为碰触梅毒患者接触过的物体(如马桶座圈和门把手)而受到感染。
梅毒能治愈吗?
能!青霉素是克星。自1943年青霉素应用于梅毒治疗后,它已成为可治愈的疾病。治疗越早,效果越好,后遗症越少。
早期梅毒(一、二期及早期潜伏):规范治疗后,治愈率极高,非特性梅毒的非特性抗体可转阴。
晚期梅毒:治疗可阻止疾病进展,消灭病原体,但对已造成的脏器损害(如心脏、神经病变)可能无法完全逆转。
关键提醒:必须去正规医疗机构,遵医嘱完成全程、足量治疗。定期复查至关重要,需随访2-3年,监测血清反应。性伴侣必须同时检查治疗,避免“乒乓球式”交叉感染。
梅毒预防牢记这几条
1.安全性行为:避免无保护的性接触,固定性伴侣,定期进行性病筛查。
2.儿童防护:杜绝用嘴喂饭、用嘴给孩子试温度、亲吻孩子口腔/面部;儿童餐具单独使用、定期消毒,避免与家人共用;若家人确诊梅毒,需及时治疗,治疗期间减少与儿童的密切接触。

3.孕检必查:孕前进行梅毒筛查,孕期定期复查。若确诊梅毒,需在医生指导下规范治疗,避免母婴传播。
4.日常防护:避免接触不明来源的血液、体液;皮肤黏膜有破损时,避免接触他人伤口或分泌物;公共场所不共用毛巾、浴巾、马桶垫等。
一旦出现疑似症状或高危接触,一定要及时就诊,早诊断、早治疗。
(来源:西南医科大学附属中医医院)
编辑:李永鑫
关注川南在线网微信公众号
长按或扫描二维码 ,获取更多最新资讯
其他